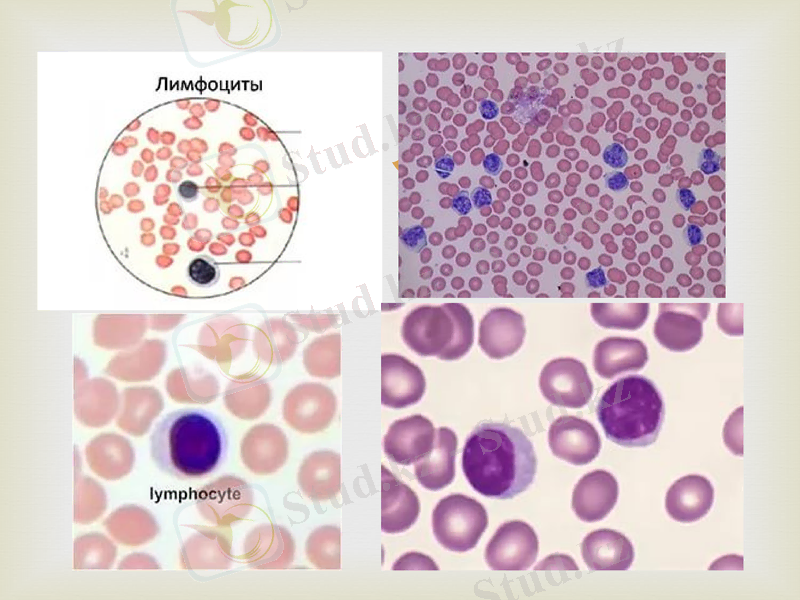
Slide 8

Иммунитеттің жасушалық және гуморалдық механизмдері мен иммуногенез патологиясы




Иммунитет дегеніміз -организмдегі генетикалық тұрғыдан бөгделермен, яғни антигендерден - микробтардан, вирустардан, бөгде торшалардан қорғау.
Антигендер дегеніміз- адам және мал организміне енгенде ерекше иммундық жауап шақыруға қабілетті күрделі органикалық заттар.

Иммундық жүйеге сүйек кемігі, тимус лимфалық түйіндер, талақ, ас қорыту жолында, өкпеде және басқа мүшелерде орналасқан лимфоидтық өрме, қан мен лимфаның лимфоциттері, дәнекер және эпителий өрмелерде әрдайым кездесетін лимфоциттер мен плазмоциттер, мононуклеарлар сондай ақ құстың Фабриций қалтасы жатады.


Иммундық реакцияға қабілетті торшалар
Иммундық реакцияларды негізінен лимфоциттер, олардан туындайтын плазмоциттер, макрофагтар және микрофагтар жүзеге асырады. Иммундық жүйеде ең негізгі тұлға - лимфоцит. Лимфоциттер торшалар жиынтығын Лимфойдтық жүйе деп атайды.

Лимфоциттер
Т -лимфоциттер
Тимусқа тәуелді
В- Лимфоциттер
Бурсаға тәуелді

Организмде 0- лимфоциттері (ноль торшалар ) деген, бетінде маркерлері жоқ, әлі жетілмеген лимфоциттер тайпасы бар, олар қор торшалар деп есептеледі.

Т-лимфоциттер
Т-лимфоциттер- тимустектес ұзақ өмір сүретін, радиация әсеріне төзімді торшалар. Иммунитеттің торшалық реакциясын жүзеге асырады, гуморальдық реакциясын жүзеге асырады, гуморальдық реакциясын реттейді, иммундық жауапқа қатысушы торшаларды демей немесе тұншықтыра әсерлейтін цитокиндерді өндіріп шығарады.
Т-лимфоциттер қандағы лимфоциттердің 70-90 % құрайды. Диаметрі 6, 5 мкм, сыртқы бетінде арнаулы антиген (0 антиген ) бар, ядросы домалақ, нығыз және қою боялады.

Т-лимфоциттер
Т-хелпер (көмек) Ил1, Ил2
Т-киллер (өлтіру)
Т - супрессор (тежеу)
Т- жады

Қандағылимфоциттердің арасында Т киллерден басқа торшалық иммундық реакцияға қатысатын табиғи -натуралды киллерлер (НК) бар. Бұл табиғи өлтірушілер бөгде торшалардан қорғанудың бірінші шепін құрып, дереу қимылдап, оларды тез арада ыдыратып жібереді. Антигенмен әсерленген бейтарап Т лимфоциттерден біршама уақыт өте келе пайда болған Т киллерлер (Тк) қорғанудың екінші шепін құрады, яғни олар антигенмен айқасқа Нк кейін түседі. Табиғи т- киллерлер диаметрі 12-15 мкм, ядросы бөлікті цитоплазмасында түйіршіктер бар лимфоциттер.

В лимфоциттер
А лимфоциттер фило- және онтогенез тұрғысынан қарағанда жас торшалар олар сүйек кемігінің діңгек торшаларынан ішектің лимфойдтық құрылымдарынан жаратылады, өмірі қысқа, радиация әсеріне өте сезімтал торшалар. Антигендік түрткіге ұшыраған В-лимфоциттер лимфобластарға, одан әрі жады лимфоциттерге және плазмоциттерге, яғни ерекше иммуноглобулиндерге (антиденелер) түзетін торшаларға айналады.

Торша диаметрі 8, 5 мкм, ядросы борпылдақтау, онша нығыз емес. Жай микросппен қараған кезде оның цитоплазмасында ядроқасылық солғын боялған жер көрінеді. В лимфоциттер қандағы лимфоциттердің 10-30 % құрайды.

Плазмоциттер
Жоғары мамандаған без торшалар, негізгі қызметі - антиденелер өндіру. Антиденелер дегеніміз- плазмоциттер түзетін, белгілі бңр антигендергме ерекше қосылуға, оларды зиянсыздандыруға қабілетті күрделі нәруыздар иммуноглобулиндер (Ig) Иммуноглобулиндердің бірнеше класстары бар
IgG, IgM, IgA, IgD, IgE

Ig M- иммуноглобулиндердің 15 % құрайды. Өмір сүру мерзімі 15-7 тәулік
Ig G - иммуноглобулиндердің 60-70 % құрайды. Өмір сүру мерзімі 14-16 тәулік
Ig Е аллергияға жауап береді.
Ig А Қан плазмасында және организмдегі секреттердің құрамында кездеседі.
Ig D Толық зерттелмеген. Ол аутиммундық аурулар кезіндекөбейеді.

Макрофагтар және Микрофагтар
Макрофагтар- қатарына қан монциті дәнекер өрме гистоциті, бауырдың жұлдызша макрофагы, өкпенің альвелалық макрофагтары, талақ, сүйек кемігі және лимфа түйіндері макрофагтары және т. б. жатады.
Микрофагтар- нейтрофильдер эозинофильдер . Аллергияа ұшырағанда және инвазиялық ауруға шалдыққанда қанда және өрмеде эозинофильдер саны көбейеді.

Иммуногенез патологиясы
Иммуногенез патологиясы - дегеніміз сенсиблизацияға ұшыраған және иммундық жүйесі жеткіліксіз организмдерде шектен тыс немесе әдеттегі міндеті өзгерген иммундық реакцияларға байланысты туынайтын сырқаттық процесстерді айтады. Олардың қатарына жергілікті аллергиялық реакцияларды, трансплантаттық иммунитеті, аутиммундық процесстерді және иммунитеттің жеткіліксіздігін жатқызадыү

Жергілікті аллергиялық өзгерістер
Белгілі бір антигенге сезімталдығы күшейген мал денесіне осы антиген қайтадан енсе аллергиялық реакция туады. Бұл реакция бес түрде іске асады.
- Іс жүргізу
- Автоматтандыру, Техника
- Алғашқы әскери дайындық
- Астрономия
- Ауыл шаруашылығы
- Банк ісі
- Бизнесті бағалау
- Биология
- Бухгалтерлік іс
- Валеология
- Ветеринария
- География
- Геология, Геофизика, Геодезия
- Дін
- Ет, сүт, шарап өнімдері
- Жалпы тарих
- Жер кадастрі, Жылжымайтын мүлік
- Журналистика
- Информатика
- Кеден ісі
- Маркетинг
- Математика, Геометрия
- Медицина
- Мемлекеттік басқару
- Менеджмент
- Мұнай, Газ
- Мұрағат ісі
- Мәдениеттану
- ОБЖ (Основы безопасности жизнедеятельности)
- Педагогика
- Полиграфия
- Психология
- Салық
- Саясаттану
- Сақтандыру
- Сертификаттау, стандарттау
- Социология, Демография
- Спорт
- Статистика
- Тілтану, Филология
- Тарихи тұлғалар
- Тау-кен ісі
- Транспорт
- Туризм
- Физика
- Философия
- Халықаралық қатынастар
- Химия
- Экология, Қоршаған ортаны қорғау
- Экономика
- Экономикалық география
- Электротехника
- Қазақстан тарихы
- Қаржы
- Құрылыс
- Құқық, Криминалистика
- Әдебиет
- Өнер, музыка
- Өнеркәсіп, Өндіріс
Қазақ тілінде жазылған рефераттар, курстық жұмыстар, дипломдық жұмыстар бойынша біздің қор #1 болып табылады.



Ақпарат
Қосымша
Email: info@stud.kz